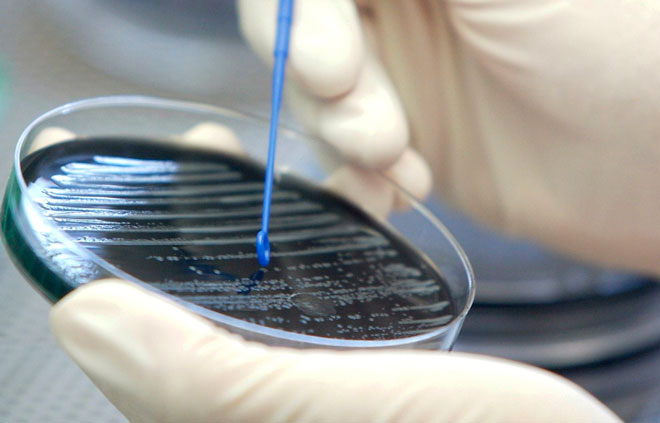

26 Nov 2015
Ozon ska rena vatten från antibiotika
Akademiska sjukhuset i Uppsala kan bli det första sjukhuset i Sverige som använder ozon för att rena avloppsvatten från antibiotika och multiresistenta bakterier. – Inom modern sjukvård är miljöansvar en viktig del och här kan Akademiska sjukhuset gå i bräschen, säger Björn Olsen, professor och infektionsläkare på Akademiska sjukhuset, i ett pressmeddelande.